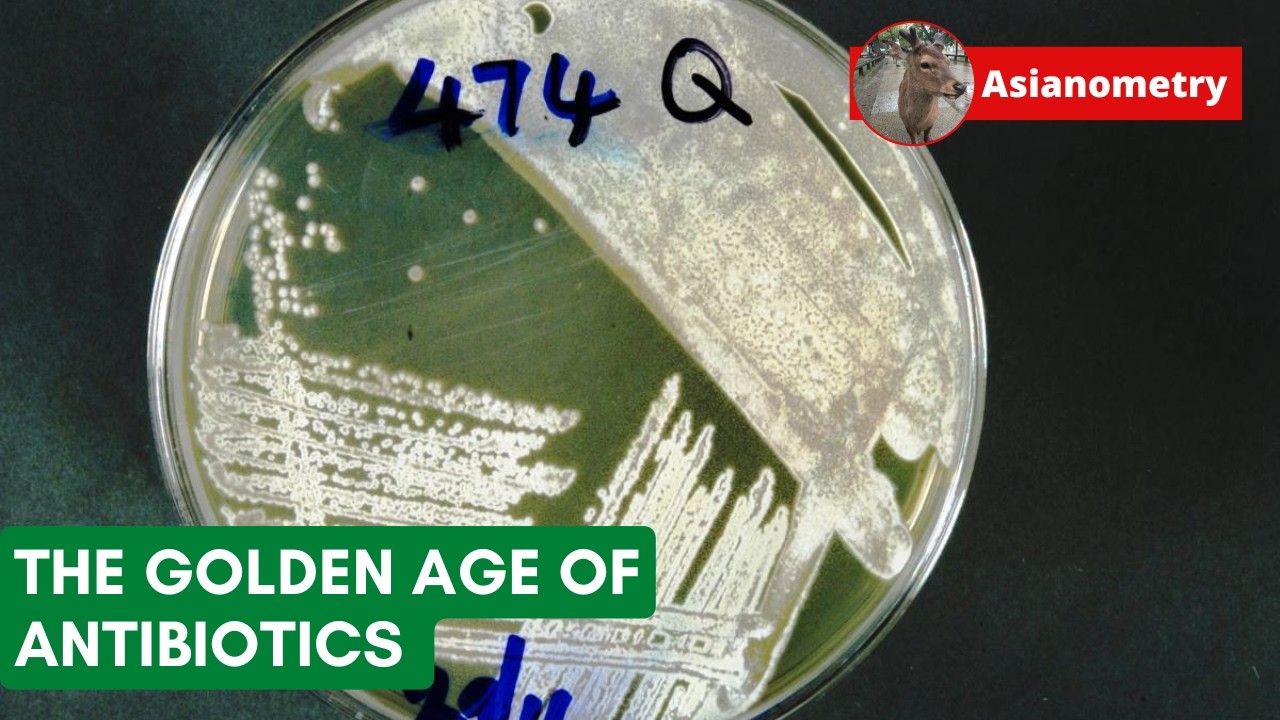
The Great Golden Age of Antibiotics

Asianometry
Источник верифицирован
Технологии
Канал Asianometry — 10 видео в базе знаний, категория: tech.
В базе с March 2026
10
видео в базе
2
методичек
933K
подписчиков
10
Видео
2
Методичек
709K
Просмотров
Методички канала
Видео в базе
10 видео
General Motors’ Robot Debacle

Sweden Brought Back DC Transmission

An Interview with Josh Fisher | Inventing VLIW, Multiflow, Itanium, VLIW's Massive Success

Fanuc and the Numerical Control Revolution

South Korea Defied the Gods to Build its Steel Colossus

Chip Fabs in Space: Technically Possible, Completely Impractical

Singapore’s Sound Card Hero
The Great Golden Age of Antibiotics

The Wildly Infectious Banana Plague
